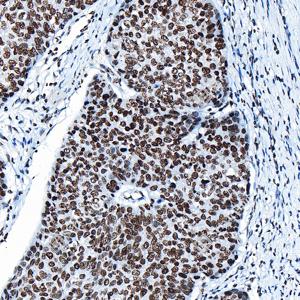
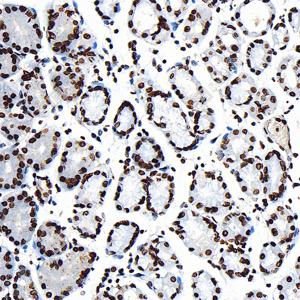

Recombinant Anti-Phospho-p70 S6 Kinase (T389) antibody (Rabbit mAb)
- 100 μL
产品信息
|
蛋白质全称 |
核糖体蛋白S6激酶β-1 |
|
别名 |
S6K-beta-1, p70 alpha, p70 ribosomal S6 kinase alpha, p70 S6 kinase alpha, p70 S6K 1, p70 S6K alpha, p70 S6KA, p70(S6K), p70(S6K) alpha, p70S6K, P70S6K1, PS6K, Ribosomal protein S6 kinase I, RPS6KB1, S6K, S6K1, STK14A |
|
Uniprot ID |
P23443 |
|
免疫原 |
人p70S6K around the phosphorylation site of T389重组蛋白 |
|
抗体亚型 |
IgG, κ |
|
克隆号 |
SB375 |
|
纯化方式 |
亲和纯化 |
|
亚细胞定位 |
细胞核, 细胞质, 线粒体 |
应用
| 应用 | 物种 | 稀释 | 阳性样品 |
| IHC/IF 免疫组织化学/免疫荧光 | 人, 小鼠, 大鼠 | 1: 1000-1: 2000 | 心, 肝, 肺 癌 |
背景
RPS6KB1(Ribosomal protein S6 kinase beta-1) is also named as STK14A, p70 S6KA and belongs to the S6 kinase subfamily. RPS6KB1 is a major substrate of MTOR and acts as a crucial effector of MTOR signaling pathway. It plays a key role in cell growth and proliferation by regulating INS sensitivity, metabolism, protein synthesis, and cell cycle. RPS6KB1 may play an important role in the progression of HCC and could serve as a potential molecular target for HCC therapy . RPS6KB1 is a 70 kDa protein and has 5 isoforms with the calculated molecular mass of 51-59 kDa produced by alternative initiation.
图像
|
|
IHC检测Phospho-p70 S6 Kinase (T389)蛋白(货号 GB153805). 样品: 人食管癌, 4%多聚甲醛 (货号G1101) 固定12-24小时. 抗原修复: 柠檬酸抗原修复液 (干粉, pH 6.0) (G1201), 高压锅均匀喷气计时2分钟. —抗: 1: 2000稀释, 4℃ 孵育过夜. 二抗: S-vision免疫组化多聚二抗(山羊抗兔),即用型 (货号G1302), 室温孵育20分钟. |
|
|
IHC检测Phospho-p70 S6 Kinase (T389)蛋白(货号 GB153805). 样品: 人胃, 4%多聚甲醛 (货号G1101) 固定12-24小时. 抗原修复: 柠檬酸抗原修复液 (干粉, pH 6.0) (G1201), 高压锅均匀喷气计时2分钟. —抗: 1: 2000稀释, 4℃ 孵育过夜. 二抗: S-vision免疫组化多聚二抗(山羊抗兔),即用型 (货号G1302), 室温孵育20分钟. |
|
|
IHC检测Phospho-p70 S6 Kinase (T389)蛋白(货号 GB153805). 样品: 小鼠心, 4%多聚甲醛 (货号G1101) 固定12-24小时. 抗原修复: 柠檬酸抗原修复液 (干粉, pH 6.0) (G1201), 高压锅均匀喷气计时2分钟. —抗: 1: 2000稀释, 4℃ 孵育过夜. 二抗: S-vision免疫组化多聚二抗(山羊抗兔),即用型 (货号G1302), 室温孵育20分钟. |
|
|
IHC检测Phospho-p70 S6 Kinase (T389)蛋白(货号 GB153805). 样品: 小鼠肝, 4%多聚甲醛 (货号G1101) 固定12-24小时. 抗原修复: 柠檬酸抗原修复液 (干粉, pH 6.0) (G1201), 高压锅均匀喷气计时2分钟. —抗: 1: 2000稀释, 4℃ 孵育过夜. 二抗: S-vision免疫组化多聚二抗(山羊抗兔),即用型 (货号G1302), 室温孵育20分钟. |
|
|
IHC检测 Phospho-p70 S6 Kinase (T389)蛋白(货号 GB153805). 样品: 大鼠肝, 4%多聚甲醛 (货号G1101) 固定12-24小时. 抗原修复: 柠檬酸抗原修复液 (干粉, pH 6.0) (G1201), 高压锅均匀喷气计时2分钟. —抗: 1: 2000稀释, 4℃ 孵育过夜. 二抗: S-vision免疫组化多聚二抗(山羊抗兔),即用型 (货号G1302), 室温孵育20分钟. |
|
|
IF检测 Phospho-p70 S6 Kinase (T389)蛋白(货号 GB153805)(绿色). 样品: 人肺癌, 4%多聚甲醛 (货号G1101) 固定12-24小时. 抗原修复: 柠檬酸抗原修复液 (干粉, pH 6.0) (G1201), 高压锅均匀喷气计时2分钟. —抗: 1: 2000稀释, 4℃ 孵育过夜. 二抗: Alexa Fluor 488标记山羊抗兔IgG (H+L) (货号GB25303), 1: 400稀释, 室温孵育1小时. |
|
|
IF检测 Phospho-p70 S6 Kinase (T389)蛋白(货号 GB153805)(绿色). 样品: 人胃, 4%多聚甲醛 (货号G1101) 固定12-24小时. 抗原修复: 柠檬酸抗原修复液 (干粉, pH 6.0) (G1201), 高压锅均匀喷气计时2分钟. —抗: 1: 2000稀释, 4℃ 孵育过夜. 二抗: Alexa Fluor 488标记山羊抗兔IgG (H+L) (货号GB25303), 1: 400稀释, 室温孵育1小时. |
|
|
IF检测 Phospho-p70 S6 Kinase (T389)蛋白(货号 GB153805)(绿色). 样品: 小鼠肝, 4%多聚甲醛 (货号G1101) 固定12-24小时. 抗原修复: 柠檬酸抗原修复液 (干粉, pH 6.0) (G1201), 高压锅均匀喷气计时2分钟. —抗: 1: 2000稀释, 4℃ 孵育过夜. 二抗: Alexa Fluor 488标记山羊抗兔IgG (H+L) (货号GB25303), 1: 400稀释, 室温孵育1小时. |
|
|
IF检测 Phospho-p70 S6 Kinase (T389)蛋白(货号 GB153805)(绿色). 样品: 大鼠肝, 4%多聚甲醛 (货号G1101) 固定12-24小时. 抗原修复: 柠檬酸抗原修复液 (干粉, pH 6.0) (G1201), 高压锅均匀喷气计时2分钟. —抗: 1: 2000稀释, 4℃ 孵育过夜. 二抗: Alexa Fluor 488标记山羊抗兔IgG (H+L) (货号GB25303), 1: 400稀释, 室温孵育1小时. |
储存
| 储存条件 | 在-20℃下储存一年, 避免反复冻融. |
| 储存缓冲液 | 含0.15% ProClin300防腐剂, 100 μg/mL牛血清白蛋白和50%甘油的磷酸盐缓冲液. |
注意:
1.本产品仅供研究使用.
2.建议用一抗稀释液(G2025)稀释本产品.
| 货号 | 名称 | 规格 | 价格 | 操作 |
|---|
| 货号 | 名称 | 规格 | 价格 | 操作 |
|---|